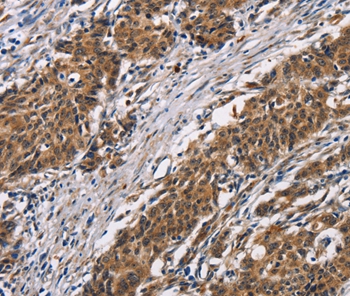
product-image-AAA303125_IHC13.jpg
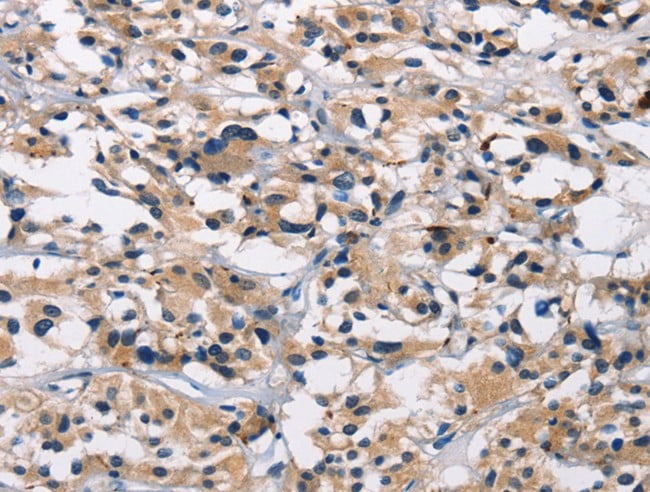
product-image-AAA166910_IHC11.jpg

Arylsulfatase B Recombinant Protein | ARSB recombinant protein
Recombinant Human Arylsulfatase B
Gene Names
ARSB; ASB; G4S; MPS6
Purity
Greater or equal to 85% purity as determined by SDS-PAGE.
Synonyms
Arylsulfatase B; N/A; Recombinant Human Arylsulfatase B; N-acetylgalactosamine-4-sulfatase; G4S; ARSB recombinant protein
Host
E Coli or Yeast or Baculovirus or Mammalian Cell
Purity/Purification
Greater or equal to 85% purity as determined by SDS-PAGE.
Form/Format
Lyophilized or liquid (Format to be determined during the manufacturing process)
Sequence Positions
37-533aa; Full Length of Mature Protein
Sequence
SGAGASRPPHLVFLLADDLGWNDVGFHGSRIRTPHLDALAAGGVLLDNYYTQPLCTPSRSQLLTGRYQIRTGLQHQIIWPCQPSCVPLDEKLLPQLLKEAGYTTHMVGKWHLGMYRKECLPTRRGFDTYFGYLLGSEDYYSHERCTLIDALNVTRCALDFRDGEEVATGYKNMYSTNIFTKRAIALITNHPPEKPLFLYLALQSVHEPLQVPEEYLKPYDFIQDKNRHHYAGMVSLMDEAVGNVTAALKSSGLWNNTVFIFSTDNGGQTLAGGNNWPLRGRKWSLWEGGVRGVGFVASPLLKQKGVKNRELIHISDWLPTLVKLARGHTNGTKPLDGFDVWKTISEGSPSPRIELLHNIDPNFVDSSPCPRNSMAPAKDDSSLPEYSAFNTSVHAAIRHGNWKLLTGYPGCGYWFPPPSQYNVSEIPSSDPPTKTLWLFDIDRDPEERHDLSREYPHIVTKLLSRLQFYHKHSVPVYFPAQDPRCDPKATGVWGPWM
Preparation and Storage
Store at -20 degree C, for extended storage, conserve at -20 degree C or -80 degree C.
Related Product Information for ARSB recombinant protein
Roves sulfate groups from chondroitin-4-sulfate (C4S) and regulates its degradation. Involved in the regulation of cell adhesion, cell migration and invasion in colonic epithelium. In the central nervous system, is a regulator of neurite outgrowth and neuronal plasticity, acting through the control of sulfate glycosaminoglycans and neurocan levels.
Product Categories/Family for ARSB recombinant protein
References
Phylogenetic conservation of arylsulfatases. cDNA cloning and expression of human arylsulfatase B.Peters C., Schmidt B., Rommerskirch W., Rupp K., Zuehlsdorf M., Vingron M., Meyer H.E., Pohlmann R., von Figura K.J. Biol. Chem. 265:3374-3381(1990) Human arylsulfatase B MOPAC cloning, nucleotide sequence of a full-length cDNA, and regions of amino acid identity with arylsulfatases A and C.Schuchman E.H., Jackson C.E., Desnick R.J.Genomics 6:149-158(1990) Structure of the human arylsulfatase B gene.Modaressi S., Rupp K., von Figura K., Peters C.Biol. Chem. Hoppe-Seyler 374:327-335(1993) Complete sequencing and characterization of 21,243 full-length human cDNAs.Ota T., Suzuki Y., Nishikawa T., Otsuki T., Sugiyama T., Irie R., Wakamatsu A., Hayashi K., Sato H., Nagai K., Kimura K., Makita H., Sekine M., Obayashi M., Nishi T., Shibahara T., Tanaka T., Ishii S., Yamamoto J., Saito K., Kawai Y., Isono Y., Nakamura Y., Nagahari K., Murakami K., Yasuda T., Iwayanagi T., Wagatsuma M., Shiratori A., Sudo H., Hosoiri T., Kaku Y., Kodaira H., Kondo H., Sugawara M., Takahashi M., Kanda K., Yokoi T., Furuya T., Kikkawa E., Omura Y., Abe K., Kamihara K., Katsuta N., Sato K., Tanikawa M., Yamazaki M., Ninomiya K., Ishibashi T., Yamashita H., Murakawa K., Fujimori K., Tanai H., Kimata M., Watanabe M., Hiraoka S., Chiba Y., Ishida S., Ono Y., Takiguchi S., Watanabe S., Yosida M., Hotuta T., Kusano J., Kanehori K., Takahashi-Fujii A., Hara H., Tanase T.-O., Nomura Y., Togiya S., Komai F., Hara R., Takeuchi K., Arita M., Imose N., Musashino K., Yuuki H., Oshima A., Sasaki N., Aotsuka S., Yoshikawa Y., Matsunawa H., Ichihara T., Shiohata N., Sano S., Moriya S., Momiyama H., Satoh N., Takami S., Terashima Y., Suzuki O., Nakagawa S., Senoh A., Mizoguchi H., Goto Y., Shimizu F., Wakebe H., Hishigaki H., Watanabe T., Sugiyama A., Takemoto M., Kawakami B., Yamazaki M., Watanabe K., Kumagai A., Itakura S., Fukuzumi Y., Fujimori Y., Komiyama M., Tashiro H., Tanigami A., Fujiwara T., Ono T., Yamada K., Fujii Y., Ozaki K., Hirao M., Ohmori Y., Kawabata A., Hikiji T., Kobatake N., Inagaki H., Ikema Y., Okamoto S., Okitani R., Kawakami T., Noguchi S., Itoh T., Shigeta K., Senba T., Matsumura K., Nakajima Y., Mizuno T., Morinaga M., Sasaki M., Togashi T., Oyama M., Hata H., Watanabe M., Komatsu T., Mizushima-Sugano J., Satoh T., Shirai Y., Takahashi Y., Nakagawa K., Okumura K., Nagase T., Nomura N., Kikuchi H., Masuho Y., Yamashita R., Nakai K., Yada T., Nakamura Y., Ohara O., Isogai T., Sugano S.Nat. Genet. 36:40-45(2004) The DNA sequence and comparative analysis of human chromosome 5.Schmutz J., Martin J., Terry A., Couronne O., Grimwood J., Lowry S., Gordon L.A., Scott D., Xie G., Huang W., Hellsten U., Tran-Gyamfi M., She X., Prabhakar S., Aerts A., Altherr M., Bajorek E., Black S., Branscomb E., Caoile C., Challacombe J.F., Chan Y.M., Denys M., Detter J.C., Escobar J., Flowers D., Fotopulos D., Glavina T., Gomez M., Gonzales E., Goodstein D., Grigoriev I., Groza M., Hammon N., Hawkins T., Haydu L., Israni S., Jett J., Kadner K., Kimball H., Kobayashi A., Lopez F., Lou Y., Martinez D., Medina C., Morgan J., Nandkeshwar R., Noonan J.P., Pitluck S., Pollard M., Predki P., Priest J., Ramirez L., Retterer J., Rodriguez A., Rogers S., Salamov A., Salazar A., Thayer N., Tice H., Tsai M., Ustaszewska A., Vo N., Wheeler J., Wu K., Yang J., Dickson M., Cheng J.-F., Eichler E.E., Olsen A., Pennacchio L.A., Rokhsar D.S., Richardson P., Lucas S.M., Myers R.M., Rubin E.M.Nature 431:268-274(2004) Mural R.J., Istrail S., Sutton G., Florea L., Halpern A.L., Mobarry C.M., Lippert R., Walenz B., Shatkay H., Dew I., Miller J.R., Flanigan M.J., Edwards N.J., Bolanos R., Fasulo D., Halldorsson B.V., Hannenhalli S., Turner R., Yooseph S., Lu F., Nusskern D.R., Shue B.C., Zheng X.H., Zhong F., Delcher A.L., Huson D.H., Kravitz S.A., Mouchard L., Reinert K., Remington K.A., Clark A.G., Waterman M.S., Eichler E.E., Adams M.D., Hunkapiller M.W., Myers E.W., Venter J.C. Human N-acetylgalactosamine-4-sulphatase protein maturation and isolation of genomic clones.Litjens T., Morris C.P., Gibson G.J., Beckmann K.R., Hopwood J.J.Biochem. Int. 24:209-215(1991) Components and proteolytic processing sites of arylsulfatase B from human placenta.Kobayashi T., Honke K., Jin T., Gasa S., Miyazaki T., Makita A.Biochim. Biophys. Acta 1159:243-247(1992) A novel amino acid modification in sulfatases that is defective in multiple sulfatase deficiency.Schmidt B., Selmer T., Ingendoh A., von Figura K.Cell 82:271-278(1995) Molecular and functional analysis of SUMF1 mutations in multiple sulfatase deficiency.Cosma M.P., Pepe S., Parenti G., Settembre C., Annunziata I., Wade-Martins R., Domenico C.D., Natale P.D., Mankad A., Cox B., Uziel G., Mancini G.M., Zammarchi E., Donati M.A., Kleijer W.J., Filocamo M., Carrozzo R., Carella M., Ballabio A.Hum. Mutat. 23:576-581(2004) Arylsulfatase B regulates colonic epithelial cell migration by effects on MMP9 expression and RhoA activation.Bhattacharyya S., Tobacman J.K.Clin. Exp. Metastasis 26:535-545(2009) Glycoproteomics analysis of human liver tissue by combination of multiple enzyme digestion and hydrazide chemistry.Chen R., Jiang X., Sun D., Han G., Wang F., Ye M., Wang L., Zou H.J. Proteome Res. 8:651-661(2009) Structure of a human lysosomal sulfatase.Bond C.S., Clements P.R., Ashby S.J., Collyer C.A., Harrop S.J., Hopwood J.J., Guss J.M.Structure 5:277-289(1997) Mucopolysaccharidosis VI (Maroteaux-Lamy syndrome) . An intermediate clinical phenotype caused by substitution of valine for glycine at position 137 of arylsulfatase B.Wicker G., Prill V., Brooks D.A., Gibson G.J., Hopwood J.J., von Figura K., Peters C.J. Biol. Chem. 266:21386-21391(1991) Mucopolysaccharidosis type VI identification of three mutations in the arylsulfatase B gene of patients with the severe and mild phenotypes provides molecular evidence for genetic heterogeneity.Jin W.-D., Jackson C.E., Desnick R.J., Schuchman E.H.Am. J. Hum. Genet. 50:795-800(1992) Mucopolysaccharidosis VI (Maroteaux-Lamy syndrome) six unique arylsulfatase B gene alleles causing variable disease phenotypes.Isbrandt D., Arlt G., Brooks D.A., Hopwood J.J., von Figura K., Peters C.Am. J. Hum. Genet. 54:454-463(1994) Four novel mutant alleles of the arylsulfatase B gene in two patients with intermediate form of mucopolysaccharidosis VI (Maroteaux-Lamy syndrome) .Voskoboeva E., Isbrandt D., von Figura K., Krasnopolskaya X., Peters C.Hum. Genet. 93:259-264(1994) N-acetylgalactosamine-4-sulfatase identification of four new mutations within the conserved sulfatase region causing mucopolysaccharidosis type VI.Simonaro C.M., Schuchman E.H.Biochim. Biophys. Acta 1272:129-132(1995) Identification, expression, and biochemical characterization of N-acetylgalactosamine-4-sulfatase mutations and relationship with clinical phenotype in MPS6 patients.Litjens T., Brooks D.A., Peters C., Gibson G.J., Hopwood J.J.Am. J. Hum. Genet. 58:1127-1134(1996) Two novel mutations of the arylsulfatase B gene in two Italian patients with severe form of mucopolysaccharidosis.Villani G.R.D., Balzano N., Di Natale P.3.0.CO;2-Q>Hum. Mutat. 11:410-410(1998) Large-scale identification, mapping, and genotyping of single-nucleotide polymorphisms in the human genome.Wang D.G., Fan J.-B., Siao C.-J., Berno A., Young P., Sapolsky R., Ghandour G., Perkins N., Winchester E., Spencer J., Kruglyak L., Stein L., Hsie L., Topaloglou T., Hubbell E., Robinson E., Mittmann M., Morris M.S., Shen N., Kilburn D., Rioux J., Nusbaum C., Rozen S., Hudson T.J., Lipshutz R., Chee M., Lander E.S.Science 280:1077-1082(1998) Maroteaux-Lamy syndrome five novel mutations and their structural localization.Villani G.R.D., Balzano N., Vitale D., Saviano M., Pavone V., Di Natale P.Biochim. Biophys. Acta 1453:185-192(1999) A novel mutation (Q239R) identified in a Taiwan Chinese patient with type VI mucopolysaccharidosis (Maroteaux-Lamy syndrome) .Wu J.-Y., Yang C.-F., Lee C.-C., Chang J.-G., Tsai F.-J.3.0.CO;2-0>Hum. Mutat. 15:389-390(2000) Mucopolysaccharidosis type VI report of two Taiwanese patients and identification of one novel mutation.Yang C.-F., Wu J.-Y., Lin S.-P., Tsai F.-J.J. Formos. Med. Assoc. 100:820-823(2001) Mutational analysis of mucopolysaccharidosis type VI patients undergoing a trial of enzyme replacement therapy.Karageorgos L., Harmatz P., Simon J., Pollard A., Clements P.R., Brooks D.A., Hopwood J.J.Hum. Mutat. 23:229-233(2004) +Additional computationally mapped references.<p>Provides general information on the entry.
NCBI and Uniprot Product Information
NCBI GI #
NCBI GeneID
NCBI Accession #
NCBI GenBank Nucleotide #
Molecular Weight
58 kDa
NCBI Official Full Name
arylsulfatase B isoform 1
NCBI Official Synonym Full Names
arylsulfatase B
NCBI Official Symbol
ARSB
NCBI Official Synonym Symbols
ASB; G4S; MPS6
NCBI Protein Information
arylsulfatase B
UniProt Protein Name
Arylsulfatase B
UniProt Gene Name
ARSB
UniProt Synonym Gene Names
ASB; G4S
UniProt Entry Name
ARSB_HUMAN
Customer Reviews
Loading reviews...
Share Your Experience
Similar Products
Product Notes
The ARSB arsb (Catalog #AAA113379) is a Recombinant Protein produced from E Coli or Yeast or Baculovirus or Mammalian Cell and is intended for research purposes only. The product is available for immediate purchase. The immunogen sequence is 37-533aa; Full Length of Mature Protein. The amino acid sequence is listed below: SGAGASRPPH LVFLLADDLG WNDVGFHGSR IRTPHLDALA AGGVLLDNYY TQPLCTPSRS QLLTGRYQIR TGLQHQIIWP CQPSCVPLDE KLLPQLLKEA GYTTHMVGKW HLGMYRKECL PTRRGFDTYF GYLLGSEDYY SHERCTLIDA LNVTRCALDF RDGEEVATGY KNMYSTNIFT KRAIALITNH PPEKPLFLYL ALQSVHEPLQ VPEEYLKPYD FIQDKNRHHY AGMVSLMDEA VGNVTAALKS SGLWNNTVFI FSTDNGGQTL AGGNNWPLRG RKWSLWEGGV RGVGFVASPL LKQKGVKNRE LIHISDWLPT LVKLARGHTN GTKPLDGFDV WKTISEGSPS PRIELLHNID PNFVDSSPCP RNSMAPAKDD SSLPEYSAFN TSVHAAIRHG NWKLLTGYPG CGYWFPPPSQ YNVSEIPSSD PPTKTLWLFD IDRDPEERHD LSREYPHIVT KLLSRLQFYH KHSVPVYFPA QDPRCDPKAT GVWGPWM. It is sometimes possible for the material contained within the vial of "Arylsulfatase B, Recombinant Protein" to become dispersed throughout the inside of the vial, particularly around the seal of said vial, during shipment and storage. We always suggest centrifuging these vials to consolidate all of the liquid away from the lid and to the bottom of the vial prior to opening. Please be advised that certain products may require dry ice for shipping and that, if this is the case, an additional dry ice fee may also be required.Precautions
All products in the AAA Biotech catalog are strictly for research-use only, and are absolutely not suitable for use in any sort of medical, therapeutic, prophylactic, in-vivo, or diagnostic capacity. By purchasing a product from AAA Biotech, you are explicitly certifying that said products will be properly tested and used in line with industry standard. AAA Biotech and its authorized distribution partners reserve the right to refuse to fulfill any order if we have any indication that a purchaser may be intending to use a product outside of our accepted criteria.Disclaimer
Though we do strive to guarantee the information represented in this datasheet, AAA Biotech cannot be held responsible for any oversights or imprecisions. AAA Biotech reserves the right to adjust any aspect of this datasheet at any time and without notice. It is the responsibility of the customer to inform AAA Biotech of any product performance issues observed or experienced within 30 days of receipt of said product. To see additional details on this or any of our other policies, please see our Terms & Conditions page.Item has been added to Shopping Cart
If you are ready to order, navigate to Shopping Cart and get ready to checkout.